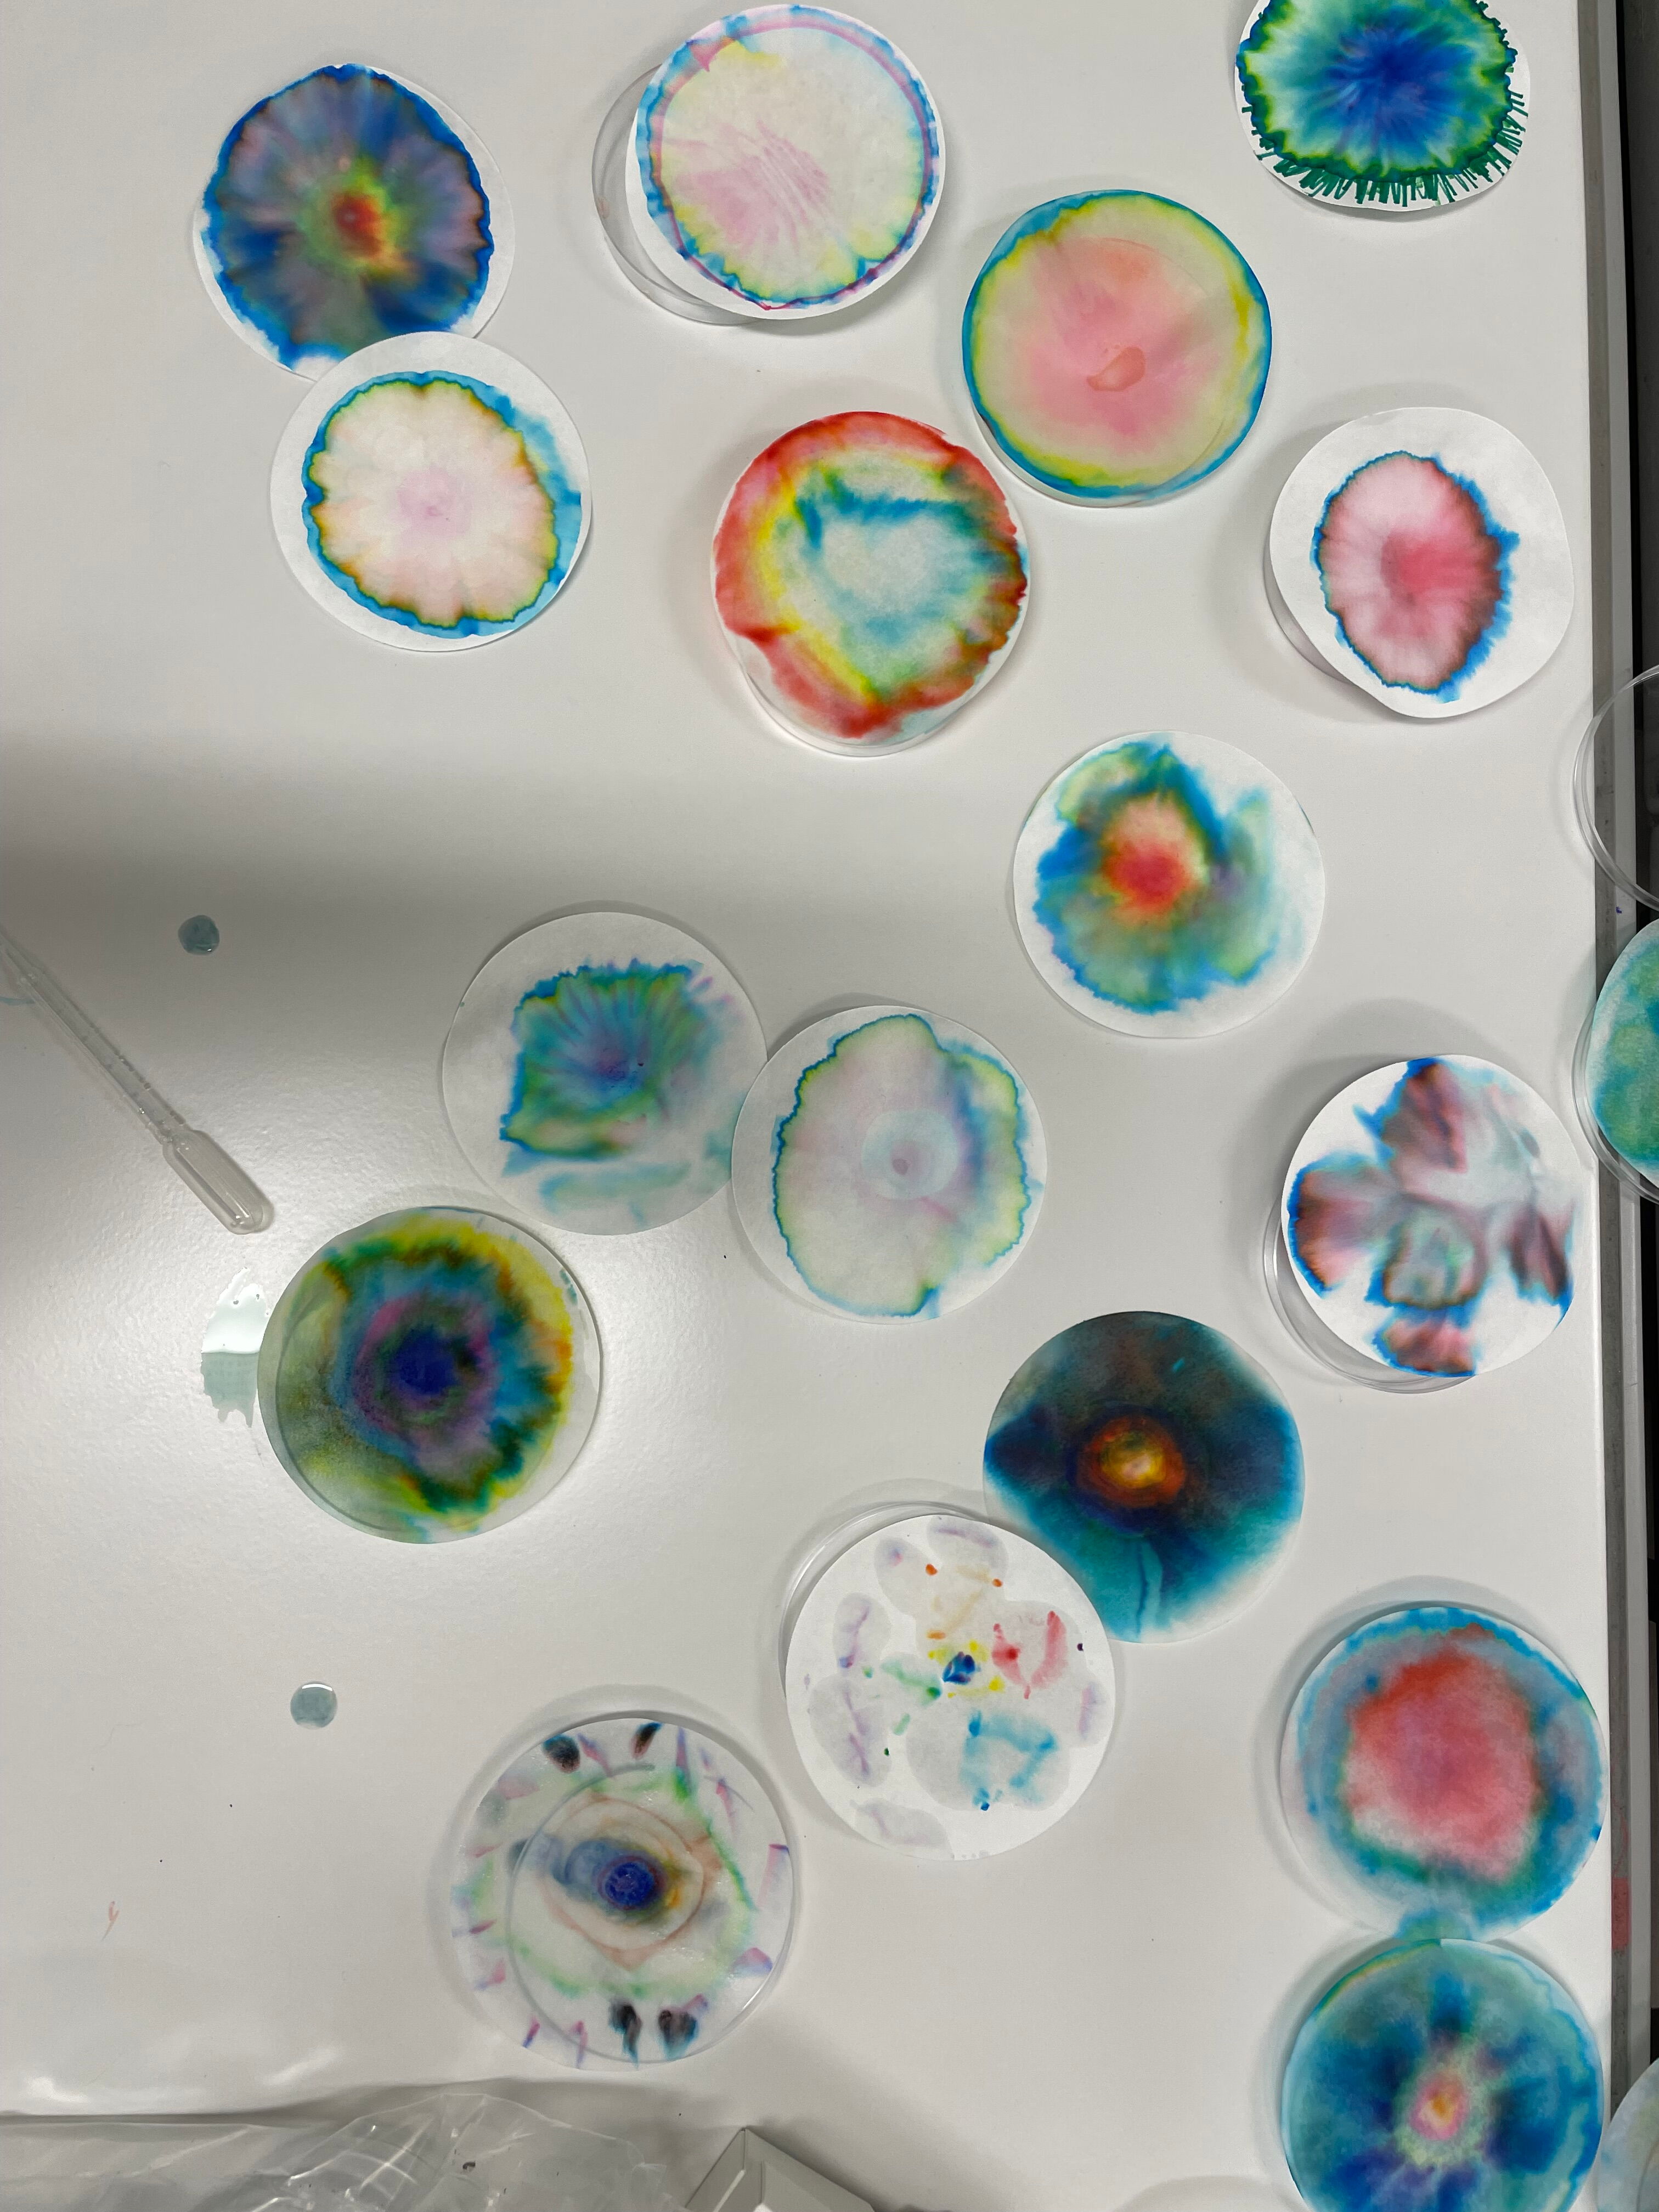

Tag der offenen Tür 2026
Im Jahr 2026 fand der Tag der offenen Tür am Donnerstag, 05. Februar 2026, von 17:00 Uhr - 20:00 Uhr statt. Die Eltern erlebten wie in den Jahren zuvor Schauunterricht, die Präsentation der vielen zertifizierten Schwerpunkte der Elisabethenschule sowie den Schwerpunkt Musik mit Chören und Orchestern. Gespräche mit Lehrkräften, Eltern und Schülerinnen und Schülern zeigten wiederum, warum an der Elisabethenschule gerne gelernt wird.
Tag der offenen Tür 2025
Im Jahr 2025 fand der Tag der offenen Tür am Freitag, 07. Februar 2025, von 17:00 Uhr - 20:00 Uhr statt. Die Eltern erlebten Schauunterricht, die Präsentation der vielen zertifizierten Schwerpunkte der Elisabethenschule sowie den Schwerpunkt Musik mit Chören und Orchestern. Gespräche mit Lehrkräften, Eltern und Schülerinnen und Schülern zeigten, warum an der Elisabethenschule gerne gelernt wird.
Tag der offenen Tür 2024

Im Jahr 2024 fand der Tag der offenen Tür am Freitag, 09. Februar 2024, von 17:00 Uhr - 20:00 Uhr statt. Die Begegnung von Lehrkräften, Eltern und Schülerinnen und Schülern der Elisabethenschule mit Schülerinnen und Schülern der 4. Klassen und ihren Eltern war das Wichtigste an diesem Tag. Der Schwerpunkt Musik konnte mit Chören und Orchestern für die Musik begeistern.
Filme über die Elisabethenschule und Präsentationen über die Schwerpunkte der Elisabethenschule vermittelten ab Dezember 2023 zusätzlich 24 Stunden am Tag an 7 Tagen in der Woche, warum man an der Elisabethenschule gerne lernt. Zudem konnte man in der Informationsbroschüre stöbern.
Tag der offenen Tür 2023

Im Jahr 2023 fand der Tag der offenen Tür wieder im üblichen Format am Freitag, 20. Januar 2023, von 17:00 Uhr - 20:00 Uhr statt. Schauunterricht und die Begegnung von Lehrkräften, Eltern und Schülerinnen und Schülern der Elisabethenschule mit Schülerinnen und Schülern der 4. Klassen und ihren Eltern war nach langer Zeit endlich möglich. Der Schwerpunkt Musik konnte mit Chören und Orchestern für die Musik begeistern.
Filme über die Elisabethenschule und Präsentationen über die Schwerpunkte der Elisabethenschule vermittelten ab Dezember 2022 zusätzlich 24 Stunden am Tag an 7 Tagen in der Woche, warum man an der Elisabethenschule gerne lernt. Zudem konnte man in der Informationsbroschüre stöbern.
Tag der offenen Tür 2022

Eine Gelegenheit -unter vielen anderen- unsere Schule kennenzulernen, war der Tag der offenen Tür am Freitag, 28. Januar2022, von 16:00 Uhr - 20:00 Uhr in Präsenz.
Filme über die Elisabethenschule und Präsentationen über die Schwerpunkte der Elisabethenschule vermittelten ab Dezember 2021 24 Stunden am Tag an 7 Tagen in der Woche, warum man an der Elisabethenschule gerne lernt. Zudem konnte man in der Informationsbroschüre stöbern.
Digitale Tage der offenen Tür 2021

Die üblichen Informationsveranstaltungen und den Tag der offenen Tür konnten wir 2021 pandemiebedingt nicht so wie in den letzten Jahren durchführen.
Wir haben deswegen im Schuljahr 2020/21 stattdessen seit 01.12.2020 rund um die Uhr 24 Stunden lang einen digitalen Tag der offenen Tür angeboten. Das bedeutete, Eltern konnten sich jederzeit ausführlich über die Elisabethenschule mit Hilfe von Videos und Präsentationen informieren. Transparenz ist an der Elisabethenschule wichtig. Daher standen Ihnen alle Informationen rund um die Uhr zur Verfügung - nicht nur an einem Tag.
Filme über die Elisabethenschule und Präsentationen über die Schwerpunkte der Elisabethenschule vermittelten, warum man an der Elisabethenschule gerne lernt.
Verschiedene virtuelle Veranstaltungen ermöglichten das gegenseitige Kennenlernen und das Beantworten individueller Fragen. Aber auch übliche Informationsquellen, wie die Broschüre der Elisabethenschule vermittelten einen Eindruck von den vielfältigen Angeboten.
Tag der offenen Tür 2020

Die beste Gelegenheit unsere Schule kennenzulernen, war am Tag der offenen Tür. Er findet einmal jährlich zu Beginn des zweiten Halbjahres statt. Im Jahr 2020 fand er noch in Präsenz am Freitag, den 14. Februar 2020, statt.